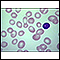

Anemia
Anemia is a condition in which the body does not have enough healthy red blood cells. Red blood cells provide oxygen to body tissues.
Different types of anemia include:
-
Anemia due to vitamin B12 deficiency
Anemia due to vitamin B12 deficiency
Anemia is a condition in which the body does not have enough healthy red blood cells. Red blood cells provide oxygen to body tissues. There are man...
 ImageRead Article Now Book Mark Article
ImageRead Article Now Book Mark Article -
Anemia due to folate (folic acid) deficiency
Anemia due to folate (folic acid) defic...
Folate-deficiency anemia is a decrease in red blood cells (anemia) due to a lack of folate. Folate is a type of B vitamin. It is also called folic ...
 ImageRead Article Now Book Mark Article
ImageRead Article Now Book Mark Article -
Anemia due to iron deficiency
Anemia due to iron deficiency
Anemia is a condition in which the body does not have enough healthy red blood cells. Red blood cells provide oxygen to body tissues. There are man...
 ImageRead Article Now Book Mark Article
ImageRead Article Now Book Mark Article -
Anemia of chronic disease
Anemia of chronic disease
Anemia is a condition in which the body does not have enough healthy red blood cells. Red blood cells provide oxygen to body tissues. There are man...
 ImageRead Article Now Book Mark Article
ImageRead Article Now Book Mark Article -
Hemolytic anemia
Hemolytic anemia
Anemia is a condition in which the body does not have enough healthy red blood cells. Red blood cells provide oxygen to body tissues. Normally, red ...
 ImageRead Article Now Book Mark Article
ImageRead Article Now Book Mark Article -
Idiopathic aplastic anemia
Idiopathic aplastic anemia
Aplastic anemia is a condition in which the bone marrow does not make enough blood cells. Bone marrow is the soft, tissue in the center of bones tha...
 ImageRead Article Now Book Mark Article
ImageRead Article Now Book Mark Article - Megaloblastic anemia
-
Pernicious anemia
Pernicious anemia
Anemia is a condition in which the body does not have enough healthy red blood cells. Red blood cells provide oxygen to body tissues. There are man...
ImageRead Article Now Book Mark Article
ImageRead Article Now Book Mark Article -
Sickle cell anemia
Sickle cell anemia
Sickle cell disease is a disorder passed down through families. The red blood cells that are normally shaped like a disk take on a sickle or crescen...
 ImageRead Article Now Book Mark Article
ImageRead Article Now Book Mark Article -
Thalassemia
Thalassemia
Thalassemia is a blood disorder passed down through families (inherited) in which the body makes an abnormal form or inadequate amount of hemoglobin....
 ImageRead Article Now Book Mark Article
ImageRead Article Now Book Mark Article
Iron deficiency anemia is the most common type of anemia.
Causes
Although many parts of the body help make red blood cells, most of the work is done in the bone marrow. Bone marrow is the soft tissue in the center of bones that helps form all blood cells.
Healthy red blood cells last between 90 and 120 days. Parts of your body then remove old blood cells. A hormone called erythropoietin (EPO) made in your kidneys signals your bone marrow to make more red blood cells.
Hemoglobin is the oxygen-carrying protein inside red blood cells. It gives red blood cells their color. People with anemia do not have enough hemoglobin.
The body needs certain vitamins, minerals, and nutrients to make enough red blood cells. Iron, vitamin B12, and folic acid are three of the most important ones. The body may not have enough of these nutrients due to:
- Changes in the lining of the stomach or intestines that affect how well nutrients are absorbed (for example, celiac disease)
Celiac disease
Celiac disease is an autoimmune condition that damages the lining of the small intestine. This damage comes from a reaction to eating gluten. This ...
 ImageRead Article Now Book Mark Article
ImageRead Article Now Book Mark Article - Poor diet
- Surgery that removes part of the stomach or intestines
Possible causes of anemia include:
- Iron deficiency
- Vitamin B12 deficiency
- Folate deficiency
- Certain medicines
-
Destruction of red blood cells earlier than normal (which may be caused by immune system problems)
Destruction of red blood cells
Anemia is a condition in which the body does not have enough healthy red blood cells. Red blood cells provide oxygen to body tissues. Normally, red ...
 ImageRead Article Now Book Mark Article
ImageRead Article Now Book Mark Article - Long-term (chronic) diseases such as chronic kidney disease, cancer, ulcerative colitis, or rheumatoid arthritis
Ulcerative colitis
Ulcerative colitis is a condition in which the lining of the large intestine (colon) and rectum become inflamed. It is a form of inflammatory bowel ...
 ImageRead Article Now Book Mark Article
ImageRead Article Now Book Mark ArticleRheumatoid arthritis
Rheumatoid arthritis (RA) is a disease that leads to inflammation of the joints and surrounding tissues. It is a long-term disease. It can also aff...
 ImageRead Article Now Book Mark Article
ImageRead Article Now Book Mark Article - Some forms of anemia, such as thalassemia or sickle cell anemia, which can be inherited
- Pregnancy
- Problems with bone marrow such as lymphoma, leukemia, myelodysplasia, multiple myeloma, or aplastic anemia
Leukemia
Leukemia is a type of blood cancer that begins in the bone marrow. Bone marrow is the soft tissue in the center of the bones, where blood cells are ...
 ImageRead Article Now Book Mark Article
ImageRead Article Now Book Mark ArticleMultiple myeloma
Multiple myeloma is a blood cancer that starts from a type of white blood cell in the bone marrow called plasma cells. Bone marrow is the soft, spon...
 ImageRead Article Now Book Mark Article
ImageRead Article Now Book Mark ArticleAplastic anemia
Aplastic anemia is a condition in which the bone marrow does not make enough blood cells. Bone marrow is the soft, tissue in the center of bones tha...
 ImageRead Article Now Book Mark Article
ImageRead Article Now Book Mark Article - Slow blood loss (for example, from heavy menstrual periods or stomach ulcers)
Stomach ulcers
A peptic ulcer is an open sore or raw area in the lining of the stomach (gastric ulcer) or in the first part of the small intestine (duodenal ulcer)....
 ImageRead Article Now Book Mark Article
ImageRead Article Now Book Mark Article - Sudden heavy blood loss
Symptoms
You may have no symptoms if the anemia is mild or if the problem develops slowly. Symptoms that may occur first include:
- Feeling weak or tired more often than usual, or with exercise
-
Headaches
Headaches
A headache is pain or discomfort in the head, scalp, or neck. Serious causes of headaches are rare. Most people with headaches can feel much better...
 ImageRead Article Now Book Mark Article
ImageRead Article Now Book Mark Article - Problems concentrating or thinking
- Irritability
- Loss of appetite
- Numbness and tingling of hands and feet
If the anemia gets worse, symptoms may include:
- Blue color to the whites of the eyes
- Brittle nails
- Desire to eat ice or other non-food things (pica syndrome)
Pica
Pica is a pattern of eating non-food materials, such as dirt or paper.
Read Article Now Book Mark Article - Lightheadedness when you stand up
- Pale skin color
-
Shortness of breath with mild activity or even at rest
Shortness of breath
Breathing difficulty may involve:Difficult breathing Uncomfortable breathingFeeling like you are not getting enough air
 ImageRead Article Now Book Mark Article
ImageRead Article Now Book Mark Article - Sore or inflamed tongue
- Mouth ulcers
- Abnormal or increased menstrual bleeding
Exams and Tests
Your health care provider will perform a physical examination, and may find:
- A heart murmur
Heart murmur
A heart murmur is a blowing, whooshing, or rasping sound heard during a heartbeat. The sound is caused by turbulent (rough) blood flow through the h...
 ImageRead Article Now Book Mark Article
ImageRead Article Now Book Mark Article - Low blood pressure, especially when you stand up
- Slight fever
- Pale skin
- Rapid heart rate
Some types of anemia may cause other findings on a physical exam.
Blood tests used to diagnose some common types of anemia may include:
- Blood levels of iron, vitamin B12, folic acid, and other vitamins and minerals
-
Complete blood count
Complete blood count
A complete blood count (CBC) test measures the following:The number of white blood cells (WBC count)The number of red blood cells (RBC count)The numb...
 ImageRead Article Now Book Mark Article
ImageRead Article Now Book Mark Article -
Reticulocyte count
Reticulocyte count
Reticulocytes are slightly immature red blood cells. A reticulocyte count is a blood test that measures the amount of these cells in the blood....
 ImageRead Article Now Book Mark Article
ImageRead Article Now Book Mark Article
Other tests may be done to find medical problems that can cause anemia.
Treatment
Treatment should be directed at the cause of the anemia, and may include:
- Blood transfusions
- Corticosteroids or other medicines that suppress the immune system
- Erythropoietin, a medicine that helps your bone marrow make more blood cells
- Supplements of iron, vitamin B12, folic acid, or other vitamins and minerals
Possible Complications
Severe anemia can cause low oxygen levels in vital organs such as the heart, and can lead to heart failure.
Heart failure
Heart failure is a condition in which the heart is no longer able to pump oxygen-rich blood to the rest of the body efficiently. This causes symptom...

When to Contact a Medical Professional
Contact your provider if you have any symptoms of anemia or unusual bleeding.
References
Elghetany MT, Banki K. Erythrocytic disorders. In: McPherson RA, Pincus MR, eds. Henry's Clinical Diagnosis and Management by Laboratory Methods. 24th ed. Philadelphia, PA: Elsevier; 2022:chap 33.
Lin JC, Benz Jr. EJ. Approach to anemia in the adult and child. In: Hoffman R, Benz EJ, Silberstein LE, et al, eds. Hematology: Basic Principles and Practice. 8th ed. Philadelphia, PA: Elsevier; 2023:chap 35.
Means Jr. RT. Approach to the anemias. In: Goldman L, Cooney KA, eds. Goldman-Cecil Medicine. 27th ed. Philadelphia, PA: Elsevier; 2024:chap 144.
-
Red blood cells - elliptocytosis - illustration
Elliptocytosis is a hereditary disorder of the red blood cells (RBCs). In this condition, the RBCs assume an elliptical shape, rather than the typical round shape.
Red blood cells - elliptocytosis
illustration
-
Red blood cells - spherocytosis - illustration
Spherocytosis is a hereditary disorder of the red blood cells (RBCs), which may be associated with a mild anemia. Typically, the affected RBCs are small, spherically shaped, and lack the light centers seen in normal, round RBCs.
Red blood cells - spherocytosis
illustration
-
Red blood cells - multiple sickle cells - illustration
Sickle cell anemia is an inherited disorder in which abnormal hemoglobin (the red pigment inside red blood cells) is produced. The abnormal hemoglobin causes red blood cells to assume a sickle shape, like the ones seen in this photomicrograph.
Red blood cells - multiple sickle cells
illustration
-
Ovalocytoses - illustration
Red blood cells (RBCs) are normally round. In ovalocytosis, the cells are oval. Other conditions that produce abnormally shaped RBCs include spherocytosis and elliptocytosis.
Ovalocytoses
illustration
-
Red blood cells - sickle and Pappenheimer - illustration
This photomicrograph of red blood cells (RBCs) shows both sickle-shaped and Pappenheimer bodies.
Red blood cells - sickle and Pappenheimer
illustration
-
Red blood cells, target cells - illustration
These abnormal red blood cells (RBCs) resemble targets. These cells are seen in association with some forms of anemia, and following the removal of the spleen (splenectomy).
Red blood cells, target cells
illustration
-
Hemoglobin - illustration
Hemoglobin is the most important component of red blood cells. It is composed of a protein called heme, which binds oxygen. In the lungs, oxygen is exchanged for carbon dioxide. Abnormalities of an individual's hemoglobin value can indicate defects in the normal balance between red blood cell production and destruction. Both low and high values can indicate disease states.
Hemoglobin
illustration
-
Red blood cells - elliptocytosis - illustration
Elliptocytosis is a hereditary disorder of the red blood cells (RBCs). In this condition, the RBCs assume an elliptical shape, rather than the typical round shape.
Red blood cells - elliptocytosis
illustration
-
Red blood cells - spherocytosis - illustration
Spherocytosis is a hereditary disorder of the red blood cells (RBCs), which may be associated with a mild anemia. Typically, the affected RBCs are small, spherically shaped, and lack the light centers seen in normal, round RBCs.
Red blood cells - spherocytosis
illustration
-
Red blood cells - multiple sickle cells - illustration
Sickle cell anemia is an inherited disorder in which abnormal hemoglobin (the red pigment inside red blood cells) is produced. The abnormal hemoglobin causes red blood cells to assume a sickle shape, like the ones seen in this photomicrograph.
Red blood cells - multiple sickle cells
illustration
-
Ovalocytoses - illustration
Red blood cells (RBCs) are normally round. In ovalocytosis, the cells are oval. Other conditions that produce abnormally shaped RBCs include spherocytosis and elliptocytosis.
Ovalocytoses
illustration
-
Red blood cells - sickle and Pappenheimer - illustration
This photomicrograph of red blood cells (RBCs) shows both sickle-shaped and Pappenheimer bodies.
Red blood cells - sickle and Pappenheimer
illustration
-
Red blood cells, target cells - illustration
These abnormal red blood cells (RBCs) resemble targets. These cells are seen in association with some forms of anemia, and following the removal of the spleen (splenectomy).
Red blood cells, target cells
illustration
-
Hemoglobin - illustration
Hemoglobin is the most important component of red blood cells. It is composed of a protein called heme, which binds oxygen. In the lungs, oxygen is exchanged for carbon dioxide. Abnormalities of an individual's hemoglobin value can indicate defects in the normal balance between red blood cell production and destruction. Both low and high values can indicate disease states.
Hemoglobin
illustration
-
Anemia
(Alt. Medicine)
-
Anemia - InDepth
(In-Depth)
Review Date: 3/31/2024
Reviewed By: Todd Gersten, MD, Hematology/Oncology, Florida Cancer Specialists & Research Institute, Wellington, FL. Review provided by VeriMed Healthcare Network. Also reviewed by David C. Dugdale, MD, Medical Director, Brenda Conaway, Editorial Director, and the A.D.A.M. Editorial team. Editorial update 12-17-2024.









